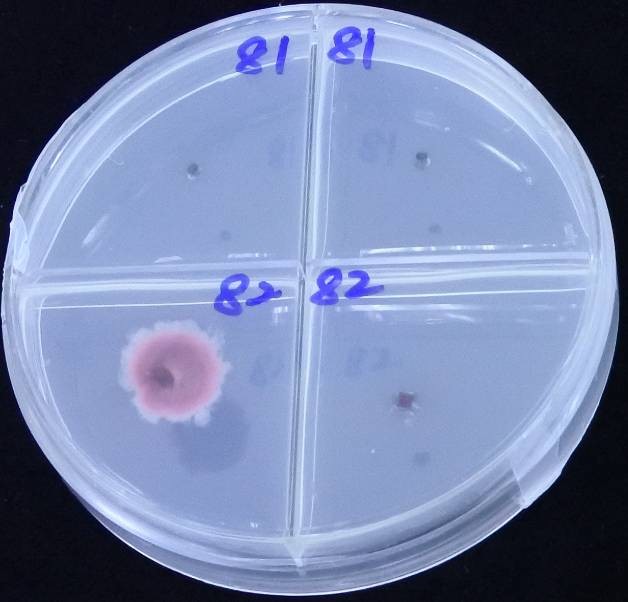
經篩檢有帶菌(紫紅色菌落)之對應編號母株即通知農民淘汰

草莓病害快速檢測技術開發及應用
發布日期:105-11-21
第105-7號
草莓病害快速檢測技術開發及應用
苗栗區農業改良場為協助農民培育健康草莓苗,近年導入病害快速檢測技術,以源頭管控方式大幅降低病害之發生。萎凋病為目前草莓育苗期重要病害,倘若植株受到病原感染,除造成種苗死亡外,或於定植本田後植株繼續發病死亡,缺株率往往達30%以上。目前草莓苗多由農民自行繁殖,因母株來自本田,潛伏病菌肉眼判斷困難,影響育苗產業甚鉅。以檢測萎凋病為例,配合農戶經2年篩檢母株及相關作業輔導,育苗期間母株發病率顯著降至0.3%,相較於未篩檢前之母株發病率9%,成效良好。
苗改場呂秀英場長表示,由於草莓苗存在萎凋病潛伏感染之問題,目前農民所遭遇最大之隱憂,在於無法由外觀判定植株是否健康;苗改場為改善產業問題,於每年7-8月提供健康草莓苗檢測服務,針對萎凋病進行快速檢測,確認未帶菌者方供翌年採種母株。
苗改場進一步指出,若選用健康植株作為育苗母株,不僅可以有效降低病害發生,在6個月的育苗期所施用之農藥亦可同步大幅減少;此外,若以農民定植草莓苗之成本效益評估,單就國內每年草莓總需苗數2,500萬株約10%因染病害之損失,透過本項篩檢技術,即可減少250萬株苗的死亡,每株若以10元估算,將可減少新臺幣2,500萬元的育苗成本投入,對於草莓果實食用安全亦大為提升。因此,導入病害快速檢測技術在培育成熟而強健之草莓種苗,為生產優質草莓之基本要件。

圖一、健康種苗為生產安全且優質草莓不可或缺之必要條件
圖二、經篩檢有帶菌(紫紅色菌落)之對應編號母株即通知農民淘汰